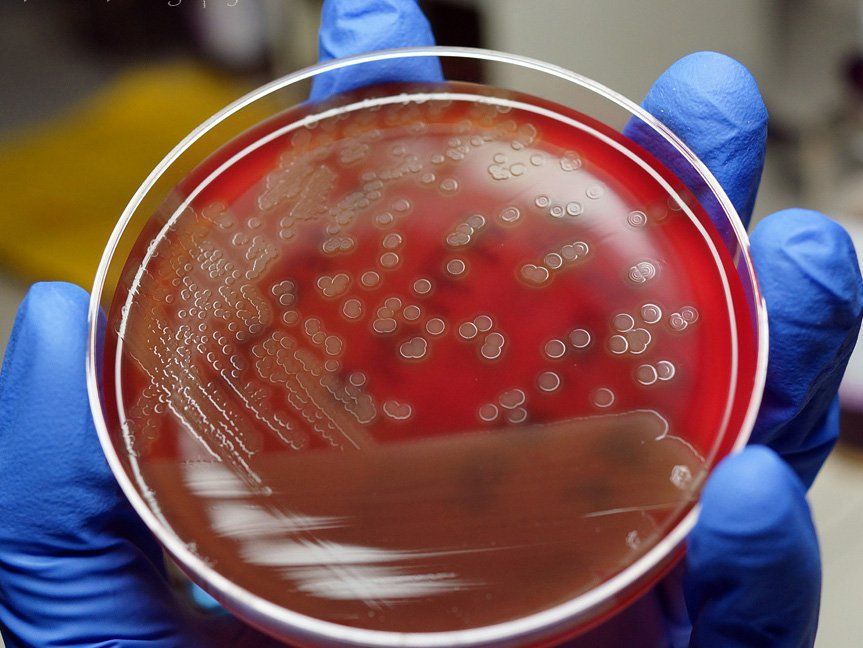
Xác định loại vi khuẩn bằng phương pháp nhuộm gram

Xác định loại vi khuẩn bằng phương pháp nhuộm gram


1. Phương pháp nhuộm gram là gì?
Nhuộm gram là phương pháp dựa trên đặc tính lý hóa của thành tế bào mà phân loại vi khuẩn thành 2 loại là vi khuẩn gram âm và vi khuẩn gram dương. Nhuộm gram có thể được thực hiện trên cả dịch cơ thể hoặc trên mẫu sinh thiết bị nghi ngờ nhiễm khuẩn.
Nhuộm gram là phương pháp xác định loại vi khuẩn nhanh hơn nuôi cấy có ý nghĩa giúp phân biệt sớm các bệnh do nhiễm khuẩn để xác định hướng điều trị cũng như tiên lượng bệnh. Các thuốc thử cần sử dụng cho phương pháp này gồm có:
- Dung dịch tím Gentian
- Dung dịch Lugol
- Cồn tẩy 950
- Dung dịch đỏ Fuchsin pha loãng 1/10
2. Quy trình nhuộm gram
Quy trình nhuộm gram sẽ gồm các bước sau:
- Dàn đều bệnh phẩm hoặc vi khuẩn lên lam kính sạch;
- Cố định mẫu bệnh phẩm bằng cách hơ trên ngọn lửa đèn cồn và để nguội;
- Các bước nhuộm:
-
- Đầu tiên phủ dung dịch tím Gentian và để khoảng 30 giây sau đó rửa dưới vòi nước chảy nhẹ. Bước này sẽ giúp nhuộm tất cả vi khuẩn thành màu tím đen
- Tiếp theo phủ dung dịch Lugol để cố định màu, cũng để khoảng 30 giây rồi rửa dưới vòi nước. Dung dịch sẽ giúp gắn màu tím vào vi khuẩn đậm hay nhạt tùy thuộc vào loại của nó
- Tẩy màu bằng cồn 950 để khoảng 30 giây và rửa nước. Đây là bước rất quan trọng để phân biệt loại vi khuẩn đã được dung dịch Lugol gắn chắc màu tím vào và loại màu tím bị tẩy trôi
- Cuối cùng phủ dung dịch đỏ Fuchsin 1/10 của Gram để khoảng 30 giây rồi rửa dưới vòi nước sẽ làm các vi khuẩn đã được tẩy hết màu tím bắt lại màu đỏ, những vi khuẩn đã bị nhuộm tím đen sẽ không bị ảnh hưởng.
-
- Để khô tự nhiên
- Soi dưới vật kính dầu
3. Cơ chế bắt màu gram của 2 loại vi khuẩn và kết quả thu được
Vi khuẩn có đặc điểm là lớp peptidoglycan dày ở thành tế bào giúp giữ các phức hợp tím tinh thể nên sau khi nhuộm gram sẽ bắt màu tím sẫm Gentian và không bị tẩy màu sau dùng cồn tẩy 950. Những vi khuẩn này sẽ được phân loại là vi khuẩn gram dương như: tụ cầu, phế cầu, liên cầu,...
Vi khuẩn có lớp peptidoglycan mỏng hơn và có thêm lớp màng lipopolysaccharide bên ngoài không thể giữ lại phức hợp tím tinh thể-iod và sẽ bị khử màu. Sau đó khi dùng dung dịch Fuchsin 1/10 phủ lên thì những vi khuẩn này sẽ bắt màu đỏ hoặc hồng. Các vi khuẩn này sẽ được phân loại là vi khuẩn gram âm.
Như vậy có thể thấy bước tẩy màu rất quan trọng và cần phải có kỹ năng nhất định vì khả năng bắt màu của Gram dương không phải là tuyệt đối.

4. Các lưu ý về nguyên nhân gây sai lệch kết quả
Vi khuẩn gram dương giả do các yếu tố sau:
- Tiêu bản được cố định khi chưa khô hoặc quá dày
- Màu của cặn thuốc nhuộm gây sai lệch kết quả
- Lugol chưa được đổ hết để cố định màu
- Cổn tẩy chưa đủ thời gian để phân biệt chính xác
- Dung dịch Fuchsin quá đậm hoặc nhuộm quá lâu
Vi khuẩn gram âm giả do các nguyên nhân như không thay Lugol hoặc tẩy cồn quá lâu và không tráng kỹ.

Ho rát họng có đờm là một vấn đề phổ biến có thể gặp ở bất kỳ ai. Nguyên nhân của tình trạng này có thể là viêm amidan, cảm cúm, viêm họng, thậm chí là ung thư vòm họng.
![[Góc giải đáp] Viêm Phế Quản Có Lây Không?](/uploads/suc-khoe/2023_12/viem-phe-quan-co-lay-khong.png&w=250&h=250&checkress=dccabc90558be2a987edc1d415786e89)
Viêm phế quản là một bệnh lý phổ biến trong xã hội ngày nay mà nhiều người có thể mắc phải. Tuy viêm phế quản không gây nguy hiểm đến tính mạng nhưng có thể ảnh hưởng đáng kể đến sức khỏe của người bệnh.

Ho, sốt đau họng là những triệu chứng thường gặp cùng lúc và có thể ảnh hưởng đến cuộc sống hàng ngày. Bài viết dưới đây sẽ làm rõ nguyên nhân, cách nhận biết và những phương pháp hiệu quả để giảm nhẹ và xua tan những triệu chứng này.

Là một phần quan trọng của hệ hô hấp, họng thường mắc phải nhiều bệnh lý khác nhau. Các bệnh về họng có thể đơn giản chỉ là viêm họng hoặc có thể nghiêm trọng hơn như viêm amidan, viêm thanh quản và thậm chí ung thư họng.

Thời điểm giao mùa, các trung tâm Y tế đang ghi nhận nhiều trường hợp bệnh nhi mắc viêm phổi do vi khuẩn Mycoplasma. Đây là một bệnh thường xuất hiện trong mùa giao mùa, đặc biệt làm lây lan nhanh chóng.


Chất tiết tế bào gốc là một loại tế bào đặc biệt có khả năng chuyển hóa thành các tế bào chuyên hóa khác trong cơ thể. Ứng dụng của chất tiết tế bào gốc có thể bao gồm điều trị các vấn đề lão hóa, chấn thương tế bào, và các bệnh lý khác.

Một trong các biện pháp để điều trị thiếu máu là điều chỉnh lại chế độ ăn uống. Người bị thiếu máu cần ăn nhiều thực phẩm giàu sắt và các vitamin khác cần thiết cho quá trình sản xuất hemoglobin và hồng cầu.

Thời tiết chuyển mùa khiến chúng ta dễ bị cảm cúm kèm theo các triệu chứng sổ mũi, đau đầu. Có nhiều loại thuốc tây có thể hỗ trợ điều trị và giảm triệu chứng nhanh chóng nhưng đây không phải sự lựa chọn của nhiều người vì sợ ảnh hưởng đến sức khỏe lâu dài. Do đó, ngày càng có nhiều người lựa chọn thảo dược trị cảm cúm và giảm các triệu chứng khó chịu mà không gây nguy hại cho sức khỏe.

Có nhiều cách kiểm soát chứng đau nửa đầu, từ dùng thuốc cho đến các biện pháp điều trị tự nhiên. Nghiên cứu gần đây cho thấy hoa oải hương có thể làm giảm chứng đau nửa đầu. Hoa oải hương có thể được sử dụng theo nhiều cách khác nhau để trị đau nửa đầu. Một trong số đó là sử dụng tinh dầu oải hương. Cùng tìm hiểu xem liệu điều trị đau nửa đầu bằng tinh dầu oải hương có hiệu quả hay không và cách sử dụng ra sao.














